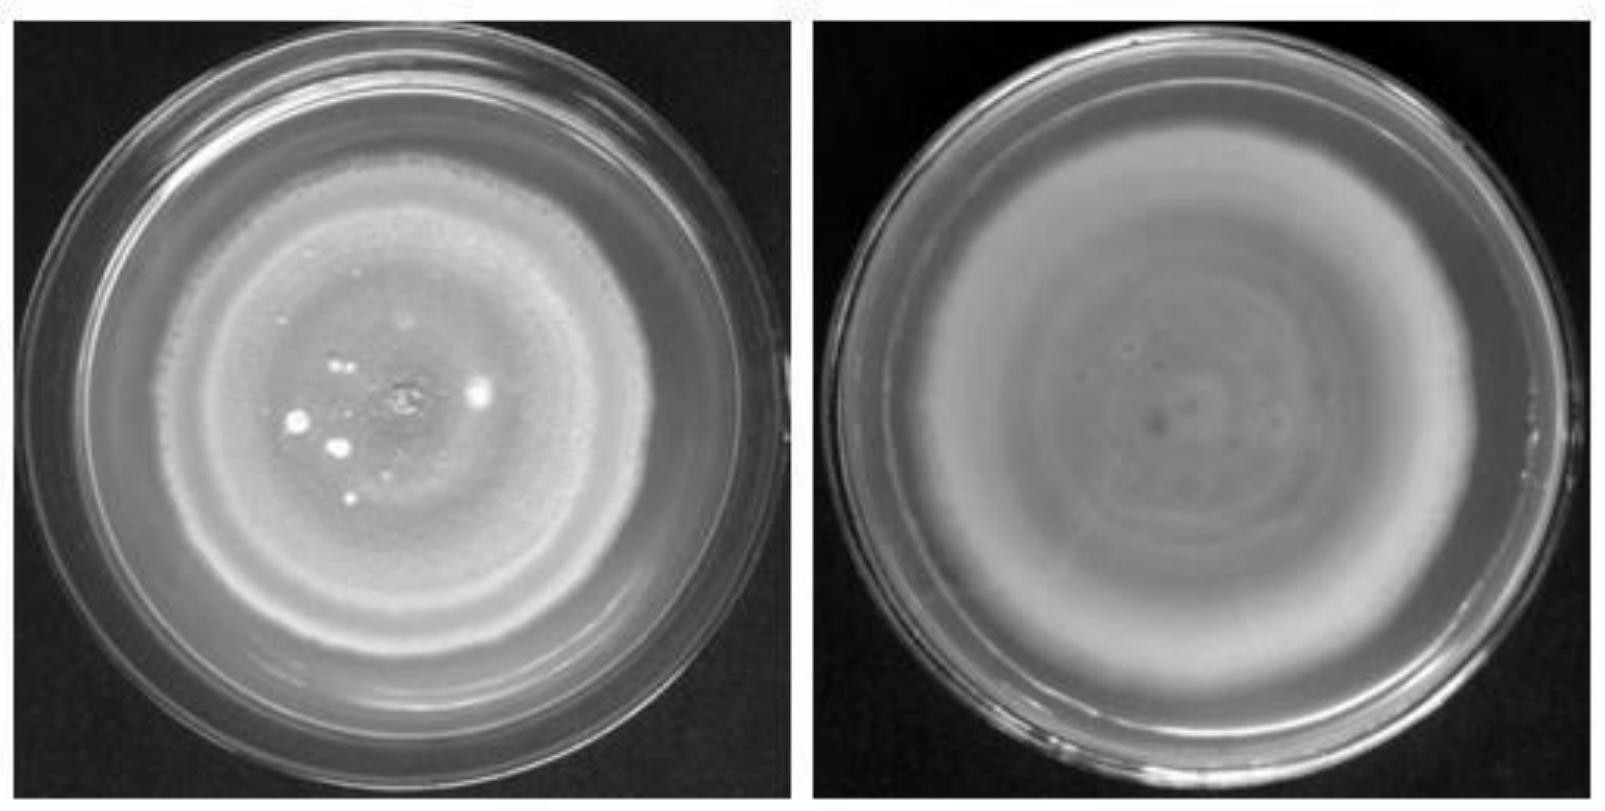
拮抗水稻白叶枯病菌的灰黄青霉pg-35菌株及其发酵滤液和在植物病害防
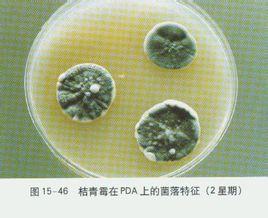
青霉

灰黄青霉

能够提取稀有金属元素的产黄青霉按照目前的技术,从废旧电池中回收锂
图片尺寸650x468
灰青 灰蓝色料>
图片尺寸400x302
到坚韧或光滑的天鹅绒状表现不等,可呈无色,白色,灰色,棕色,黑色,黄色
图片尺寸2736x2736
上图从上至下,从左至右依次为金灰青霉,黄暗青霉,纯绿青霉,岛青霉木
图片尺寸662x666
(灰霉病菌危害黄瓜)
图片尺寸1080x811
灰黄霉素片
图片尺寸520x596
拮抗水稻白叶枯病菌的灰黄青霉pg-35菌株及其发酵滤液和在植物病害防
图片尺寸1605x811
青霉
图片尺寸268x218
p>灰黄毒素是由许多种青霉,如灰黄青霉(peniciltiurn yiseoful-tern)
图片尺寸555x366
微生物产生的 细菌:杆菌肽,短杆菌肽 ,多粘菌素等(占13%) 真菌:青霉素
图片尺寸1080x810
你好请问大棚地面青藓上长灰色菌丝,平时大棚比较阴湿,灰掠昃突岢
图片尺寸826x1102
手喷油自灰喷漆漆漆灰色系列中灰银i灰浅灰哑光黑灰深动黄灰
图片尺寸300x300
辉煌手绳灰黄5010加5016
图片尺寸1080x1439
好色专家极致灰亮丽黄colorvisual
图片尺寸1080x1033
过敏性紫癜有哪些表现?
图片尺寸1080x1080
灰黄霉素头癣治头癣
图片尺寸300x299
灰黄霉素_远成99%灰黄霉素 126-07-8 抗真菌
图片尺寸598x410
灰黄霉素人用灰黄霉素软膏甲癣抗真菌灰黄霉素头癣治头癣药膏外用
图片尺寸300x300
有图有真相,史上最全苹果病害图谱!
图片尺寸567x300
旧物改造瓶子丙烯画莫兰迪灰黄教程
图片尺寸1080x1440